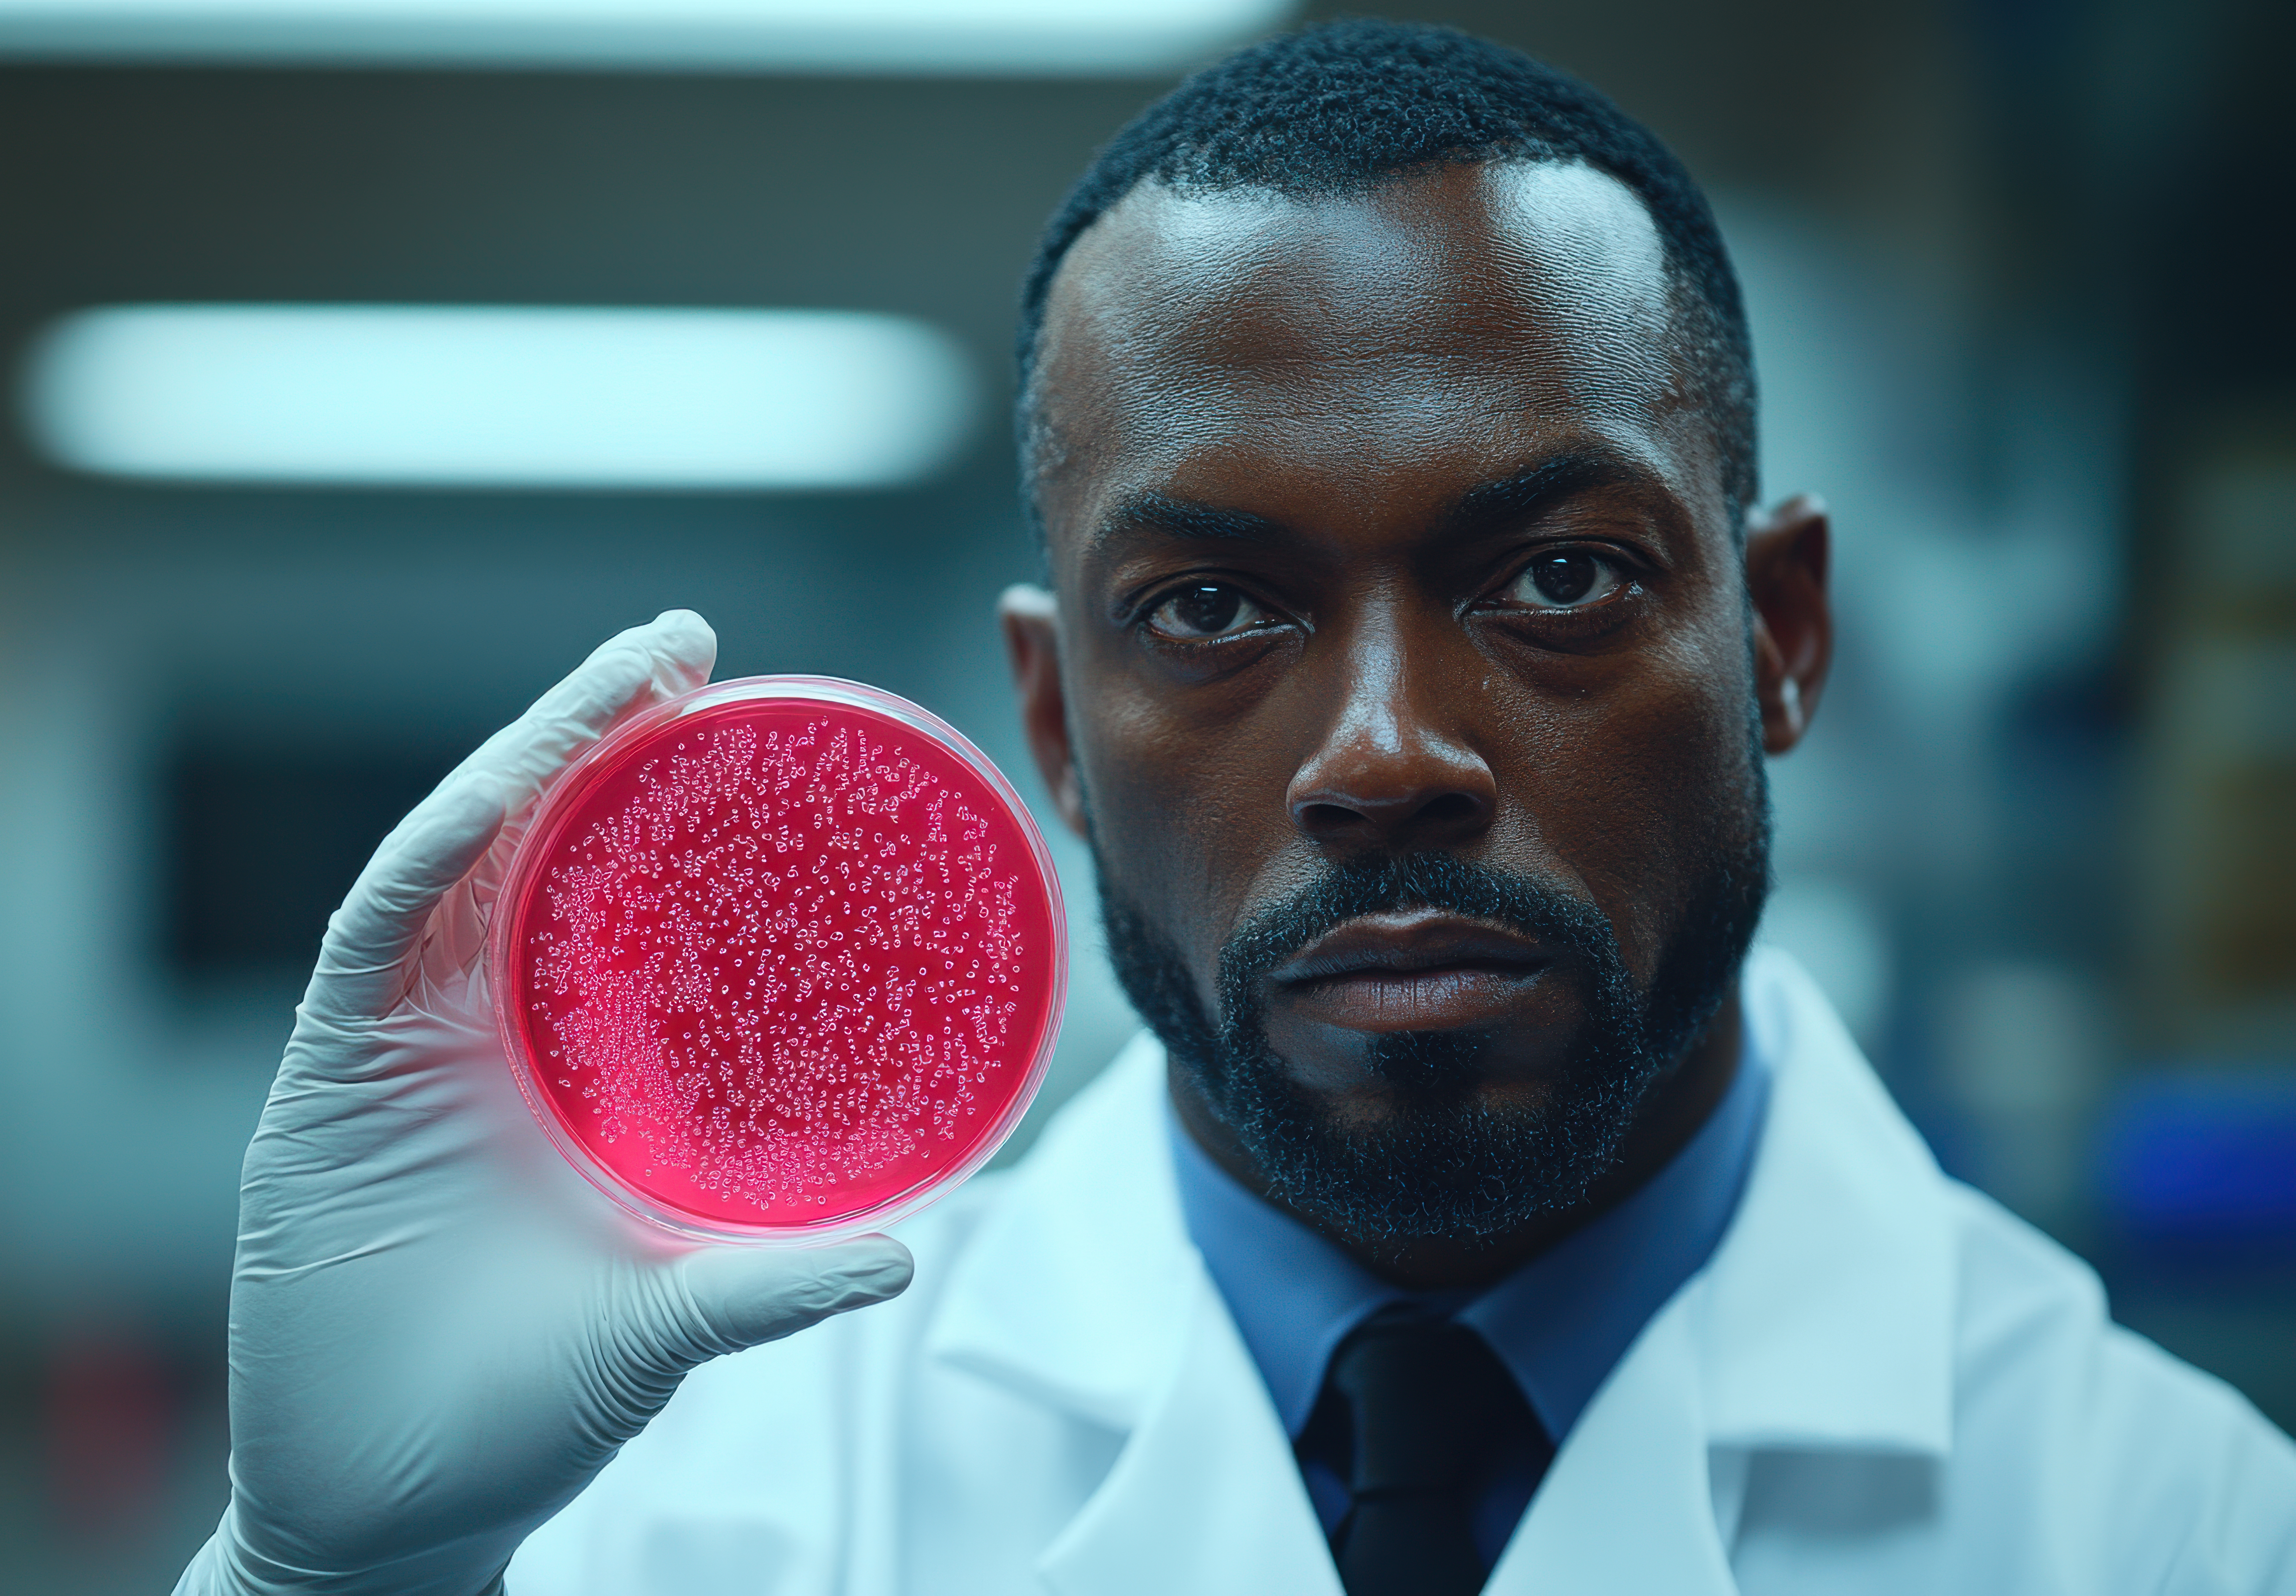
close up portrait of a scientist examining a petri dish in a laboratory

About
Oasis Cancer Research Institute (OCRI)
Oasis Cancer Research Institute (OCRI) is Somalia’s first dedicated cancer research institute, established under Oasis Group, founders of the country’s first Cancer Hospital.
We advance cancer knowledge, strengthen Somali research capacity, and build a foundation for evidence-based cancer control in low- and middle-income countries. Our work drives local innovation, fosters collaboration, and paves the way for a healthier future.
- Cancer Research & Data
- Capacity Building for Somali Researchers
- Ethical & Evidence-Based Studies
Featured Rotating Highlights
Somalia’s First Cancer Registry (Pilot 2026)
Launching the first-ever national cancer registry to systematically collect data on cancer cases — a critical foundation for evidence-based cancer control and planning in Somalia.
Research on HBV & Liver Cancer
Investigating the link between Hepatitis B Virus (HBV) and liver cancer in Somalia to improve early detection, vaccination strategies, and public health outcomes.
KAP Study on Cancer Awareness (2025)
A nationwide survey assessing Knowledge, Attitudes, and Practices (KAP) related to cancer prevention, screening, and treatment — guiding future awareness and policy programs.
Capacity Building for Young Researchers
Empowering the next generation of Somali scientists through training, mentorship, and hands-on research experience in cancer studies and data analysis.

Make a Difference with OCRI
Every contribution helps us advance cancer research,
train young scientists, and
strengthen Somalia’s fight against cancer.
Be part of the movement that turns research into real impact.

